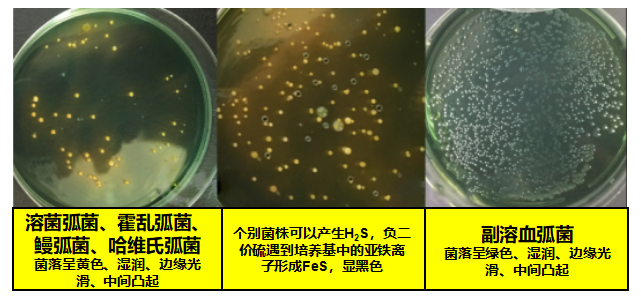

国产女人高潮毛片-伊人情涩网-亚洲欧美日韩在线精品2024-久久精品AⅤ无码中文字字幕-人妻日本无中文字幕无码
地址:山东省.泰安市.泰前
电 话:0538-8505866
传 真:0538-8505966
财富热线:18660886576
近几年,南美白对虾养殖在放苗30天左右出现“急性肝胰腺坏死”的现象日趋严重,会导致很多塘口出现不同程度的偷死情况。经过公司技术员多地走访观察得出,其发病的主要原因之一是“弧菌”感染,“弧菌”也被称为南美白对虾养殖的头号杀手,其危害性大,但是并非不可控,所以前期南美白对虾塘的管理至关重要。
01
什么是弧菌
弧菌是池塘环境中常见的细菌类群之一,广布于河口海区以及海洋生物体中。目前养殖南美白对虾易受感染的弧菌种类主要有:哈维氏弧菌(育苗阶段容易出现,虾子发荧光)、溶藻弧菌(红体,白斑)、副溶血性弧菌(肝脏肿大,萎缩,空肠、空胃,红体、白斑)、霍乱弧菌(肠炎白便)。
弧菌的共性特点:
1、革兰氏阴性菌。
2、兼性厌氧,多存在于水中。
3、条件致病菌。
02
对虾感染弧菌的发病条件
对虾的发病条件即环境突然改变(水质突变、底质恶化、虾子顶塘等问题),导致虾体应激,使得虾子体质减弱,诱发正常虾潜伏感染病菌;持续应激得不到缓解就会导致池塘中部分潜伏感染病菌的虾子转为急性感染,继而发病死亡。此时,健康的虾子会摄食病死虾,这样以点带面,导致池塘虾病爆发。
03
如何防控弧菌感染
1. 稳水
稳水讲究的是菌藻平衡,避免水体理化指标剧烈波动,从而避免对虾应激。要想稳水,要菌藻同时进行调控。根据需要进行补菌和肥水的操作。可使用EM菌,本品菌种含量高、活力旺、繁殖快,施入水体后能在短时间内形成有益优势菌群,同时可分解水体中的大分子有机物,释放氮、磷、钾等元素,促进有益藻类的繁殖生长,调爽水色。
2. 净底
鱼虾混养池塘在5-9月份是投料的高峰期,这个时间段残饵粪便大量积累,水体有机质也急剧上升,再加上此时正处在高温季节,病菌滋生快。因此,这一时期需要重视池塘底部健康。定期使用过硫酸氢钾复合盐进行改底,氧化底泥,偿还氧债。
3. 壮虾
虾子的一道防线是外壳,所以硬壳在整个养殖过程中都是一个相当重要的环节。硬壳阶段需要大量的矿物质元素,池塘中矿物质的量和种类够不够都是难以预料的,所以可在对虾集中脱壳期往池塘中补充钙磷双补或羟基丙酸钙钙,以减少软壳带来的染病风险。
4. 抑弧菌
使用过硫酸氢钾复合盐对水体进行消毒,该产品为50%过硫酸氢钾复合盐,对控制弧菌有显著的效果,而且在消毒杀菌的过程中还可以释放氧气,提高池塘溶解氧,改善池塘环境;间隔24小时后,再全池泼洒强化菌克,能有效控制养殖动物体内外弧菌的滋生,以防弧菌的复发,使水体内弧菌的数量长时间保持在一个较低的水平。
公司技术团队在市场进行了弧菌普查,通过前后对比揭示了过硫酸氢钾复合盐在防控弧菌方面的强大作用。
一般认为,池塘水体弧菌的警戒线为300cfu/ml,弧菌普查结果显示,有85%的未消毒池塘水体弧菌超标。同时,我们发现,使用过硫酸氢钾复合盐消毒的池塘,少的弧菌含量为10cfu/ml,平均弧菌含量为80cfu/ml。
04
总结
弧菌是条件致病菌,所以在日常管理中,调理好水质、池塘底质环境、提高养殖动物免疫力和定期消毒保持池塘底部容氧,是预防和控制弧菌爆发不可缺少的步骤。